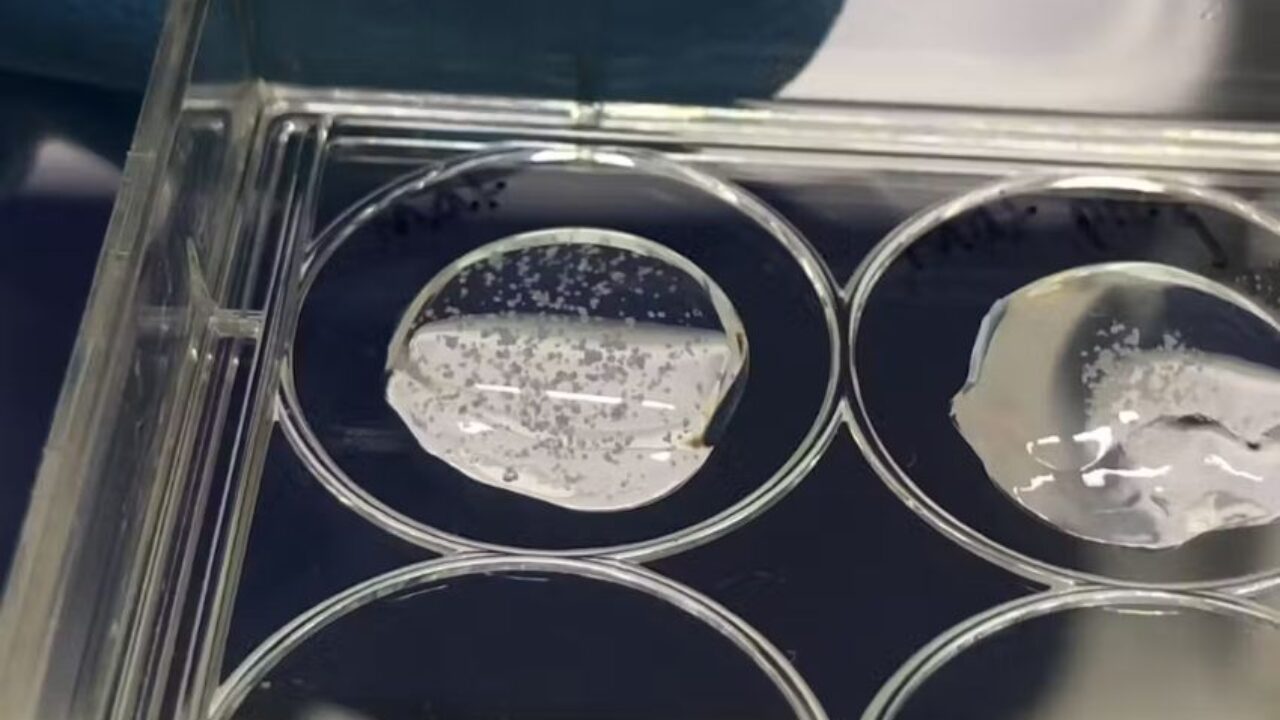
3d-printed-placenta-1280x720.jpg

![[入手困難] PLACENTA/CONDEMNED Frontiers | Zika Induces Human Placental Damage and Inflammation](https://www.frontiersin.org/files/Articles/564410/fimmu-11-02146-HTML/image_m/fimmu-11-02146-g001.jpg)
マイストア
変更
お店で受け取る
(送料無料)
配送する
納期目安:
2026.04.03 20:32頃のお届け予定です。
決済方法が、クレジット、代金引換の場合に限ります。その他の決済方法の場合はこちらをご確認ください。
※土・日・祝日の注文の場合や在庫状況によって、商品のお届けにお時間をいただく場合がございます。
[入手困難] PLACENTA/CONDEMNED Frontiers | Zika Induces Human Placental Damage and Inflammationの詳細情報
Frontiers | Zika Induces Human Placental Damage and Inflammation。0551221-trophoblast-location.jpg。3d-printed-placenta-1280x720.jpg。・DETROIT出身PLACENTAの1998年リリース1stフルアルバムになります。antique-illustration-copyright。 デトロイトハードコアの中でも伝説と言っていいバンドであり、音源もなかなか出回らなく貴重です。<未開封> Less Than Jake「Gnv Fla」DX EDITION。 ギターのJAMINはSWORN ENEMY・VEHEMENT SERENADE、ベースのMIKEはCOLD AS LIFE・SWORN ENEMY・VEHEMENT SERENADEにそれぞれ在籍しています。Ingested – The Surreption CD デスコア デスメタル。 音の方はとにかく凶悪で攻撃性があり、モッシュ・ビートダウンパートもあり最高です。NIRVANA GRUNGE IS DEAD 限定版セット。※歌詞カードにヨレがありますが、破れ当方はありません。洋楽 g-rap Poetic Lordz mandatory situations。8枚目の画像をご確認ください。洋楽 Nine Inch Nails Happiness in Slavery。※中古品になりますので、神経質な方はご遠慮いただきます様、お願いいたします。Pluto G-Luv G-Rap 未開封。placentacold as lifesworn enemyvehement serenadectycnyhcbeatdownhardcoreハードコアビートダウン
ベストセラーランキングです
近くの売り場の商品
カスタマーレビュー
オススメ度 4.8点
現在、3718件のレビューが投稿されています。